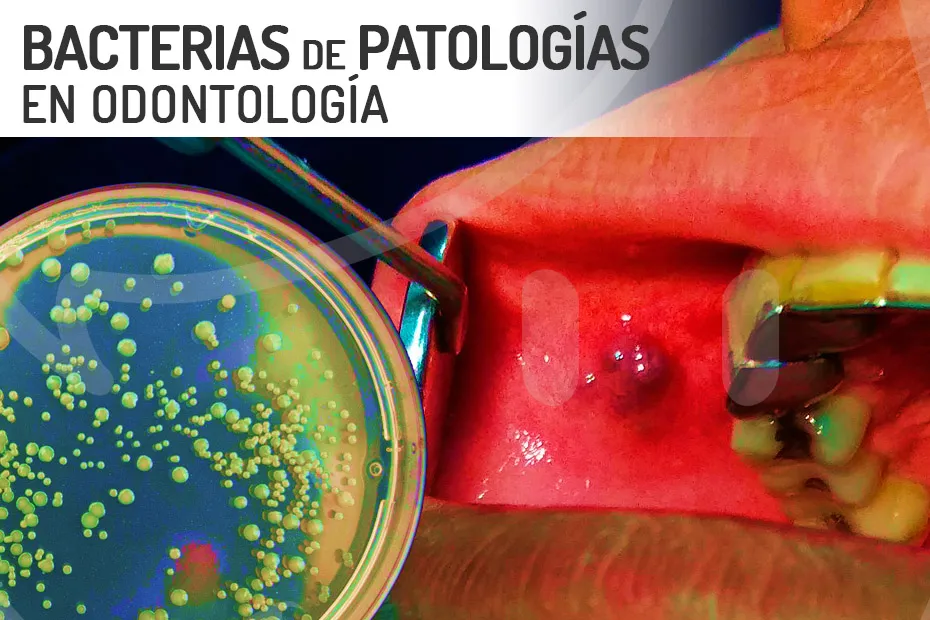

Cedido By Copyright © 2022. Ediciones de Salud, Nutrición y Bienestar, SL
Vino tinto para matar las bacterias de las encías.
Estimado Lector,
Si disfruta del placer de una copa de vino tinto de vez en cuando, la próxima vez que visite a su dentista puede decirle orgulloso que ha estado trabajando concienzudamente para prevenir la enfermedad periodontal (enfermedad de las encías).
Según los resultados de una nueva investigación, el vino tinto eliminó dos tipos de bacterias que causan la gingivitis o periodontitis. Esas son buenas noticias si le gusta beber una copa de Rioja o Ribera de Duero con la cena.
Pero esto no es exactamente sorprendente. Ya hubo un estudio similar hace casi 20 años. En aquel estudio, los investigadores atribuyeron la prevención de la enfermedad de las encías a los polifenoles que se encuentran en las semillas de las uvas.
No es ninguna coincidencia. De hecho, en este nuevo estudio, cuando se agregó extracto de semilla de uva al vino, el líquido resultante fue incluso más efectivo que el vino por sí solo para combatir la gingivitis. Ello es porque mató no dos, sino tres tipos de bacterias causantes de la gingivitis.
Ahora usted sin duda está pensando que no va a estropear su copa de vino añadiéndole un toque de extracto de semillas de uva… y estoy de acuerdo con usted. Lo que puede hacer es tomar las dos cosas por separado: su copa de vino por un lado y por otro el extracto de semillas de uva.
Lo bueno es que estará haciendo por su salud mucho más que mantener sus encías saludables.
Y es que las semillas de uva ofrecen una lista impresionante de beneficios, como por ejemplo:
- Mejora de la salud de las arterias, incluidos los vasos sanguíneos finos (microcirculación).
- Reducción de la inflamación del hígado (menor riesgo de enfermedad del hígado graso no alcohólico).
- Mejor control del azúcar en la sangre.
- Niveles más bajos de proteína C reactiva (un marcador de inflamación).
- Reducción del dolor abdominal y otros síntomas de pancreatitis crónica.
La mayoría de los estudios sobre la enfermedad periodontal se centran en el beneficio del vino. Algunos ni siquiera mencionan el extracto de semilla de uva. Pero como ha visto, ese es el verdadero protagonista.
Así que disfrute de su copa de vino, pero no pase por alto los beneficios del extracto de semillas de uva.
Le deseo la mejor salud.
Artículo recopilado por Niklauss para CatSeguros.net.
Fuente:












